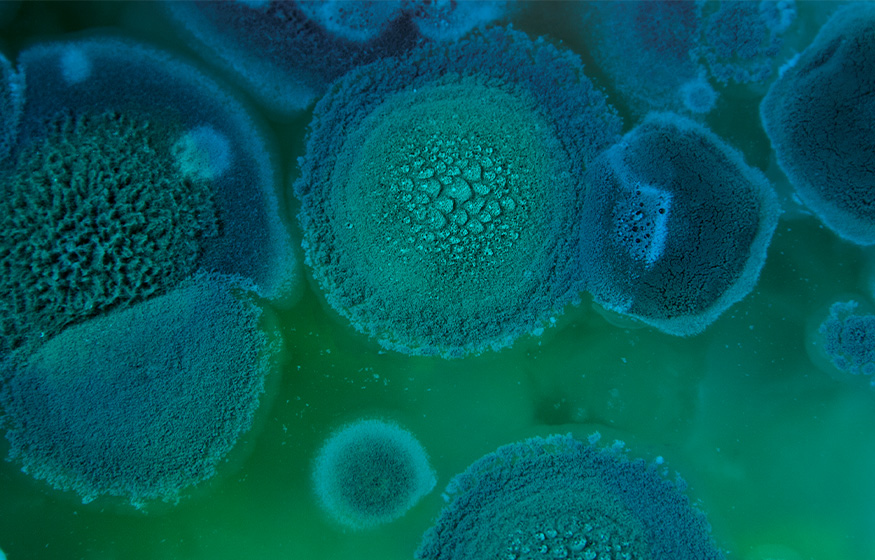
Aspergillus fumigatus

Our Services
E. cuniculi Testing
As a main focus of our client research program, our serologic and acute phase protein test options can aid in the diagnosis and prognosis of this disease.
Learn More About E. cuniculi
Aspergillus Serodiagnostics
Laboratory developed tests can help with diagnosis and prognosis of this opportunistic pathogen in avian species and dolphins. Novel diagnostic tests are available.
Aspergillus Serodiagnostics
Protein Electrophoresis
This big picture of the acute phase response can aid in health assessments and prognosis. Electrophoresis is an essential part of all routine bloodwork and infectious disease panels.
Understanding Protein Electrophoresis
Acute Phase Proteins
Drilling down to specific acute phase proteins brings sensitivity to detecting and monitoring inflammation and response to treatment.
Acute Phase Proteins - A Primary Tool
All Species Welcome!
More than 25 years of experience and excellence in diagnostic testing for non-traditional species. This is what we are all about – personalized testing, active clinical research program, giving back to avian, exotic, and wildlife medicine.
All Species Welcome